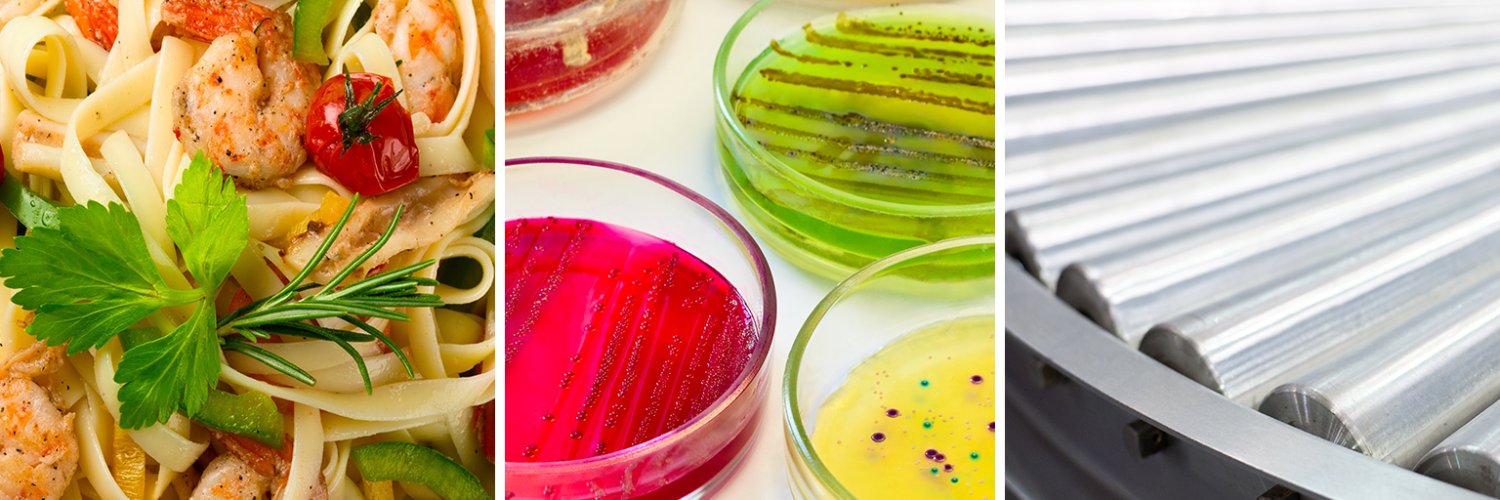
EFFoST banner

🏅 #EFFoST proudly congratulates Dr. Huub Lelieveld on receiving the 2026 World Food Prize.
For more than six decades, Huub has contributed to improving food safety, hygienic food processing and international cooperation across the food industry.
👉🏼ow.ly/eHSi50Z2EH5

English